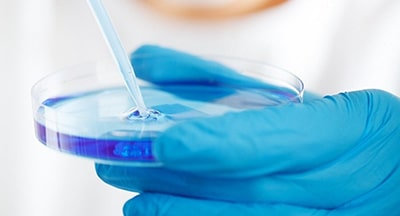

![]()
На сегодняшний день донация яйцеклетки помогает становиться мамами многим женщинам по всему миру. Но на самом деле появилась она совсем недавно, и это был прорыв в репродуктивных технологиях!
Первый ребенок с использованием донации яйцеклетки появился в Австралии в 1983 году. Практически одновременно (3 февраля 1984 года) в США также родился ребенок, зачатый с использованием яйцеклетки донора.
Это было особое событие, ведь новая технология, сделала возможным рождение ребенка в семьях, которые раньше не могли иметь детей из-за женского бесплодия или повышенного риска передать наследственное заболевание. Донорство яйцеклеток дало надежду многим женщинам, что они смогут стать мамами!
Стать родителями всем, кто этого очень хочет, помогает еще одна новейшая репродуктивная услуга, которую часто применяют вместе с донацией яцеклетки – суррогатное материнство. В этом случае созданный «в пробирке» эмбрион помещается в полость матки суррогатной матери - женщины, которая обязуется выносить и родить этого ребенка, после чего передать семье, для которой было осуществлено вынашивание.
Женщины, которые готовы предоставить свою яйцеклетку или выносить ребенка для другой пары, делают очень важное и благородное дело. Они оказывают неоценимую помощь парам, которые мечтают о пополнении семьи!
Однако внедрение новейших репродуктивных технологий не везде проходит одинаково быстро и гладко. Еще существуют предубеждения против подобных методов. Это создает сложности и поэтому во многих странах донация яйцеклеток запрещена или применяется с большими ограничениями.
На сегодняшний день донация яйцеклеток запрещена законом в Германии, Австрии, Швейцарии и Италии. В большинстве других стран доноры яйцеклеток могут легально передавать свой генетический материал семьям для использования в ЭКО, но во многих странах есть свои юридические нюансы использования донации яйцеклеток. Так в Нидерландах и Австралии родители обязаны рассказать ребенку информацию о доноре яйцеклеток, как только он их об этом спросит. А, например, в Великобритании донация яйцеклеток оплачивается очень скромно. Подобные нюансы приводят к тому, что получить донорскую яйцеклетку оказывается достаточно сложно и парам, желающим воспользоваться этой услугой приходится несколько лет стоять в очереди.
Тем не менее, есть страны, где созданы наиболее благоприятные условия для применения донации яйцеклетки в качестве репродуктивной технологии. Например, в США эта технология «работает» очень активно – на сегодняшний день донорская яйцеклетка в США использовалась примерно у 18% детей, рожденных в результате проведения ЭКО.
Донация яйцеклеток в Украине официально признана, как средство лечения бесплодия, и для ее использования созданы наиболее благоприятные условия.